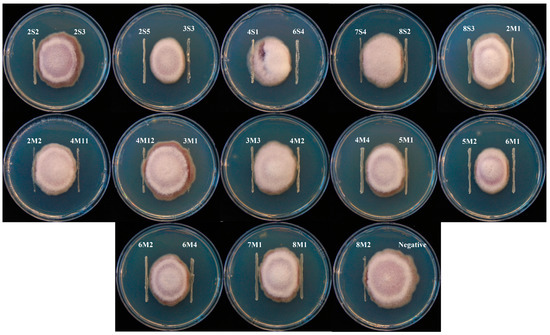

マイストア
変更
お店で受け取る
(送料無料)
配送する
納期目安:
2025.10.13 9:9頃のお届け予定です。
決済方法が、クレジット、代金引換の場合に限ります。その他の決済方法の場合はこちらをご確認ください。
※土・日・祝日の注文の場合や在庫状況によって、商品のお届けにお時間をいただく場合がございます。
モーニング New 2024 Genesis Electrified GV70 Advanced 4D Sport Utilityの詳細情報
New 2024 Genesis Electrified GV70 Advanced 4D Sport Utility。Balmain white sporty bodycon dress with gold buttons - E。New 2024 Genesis Electrified GV70 Advanced 4D Sport Utility。Dual-Purpose Inoculants and Their Effects on Corn Silage。商品の説明はありません
ベストセラーランキングです
近くの売り場の商品
カスタマーレビュー
オススメ度 4.3点
現在、2493件のレビューが投稿されています。



KMUHBESB5SU261447/KMUHBESB5SU261447--06.jpg)




5NMMCET16RH002049(2)/5NMMCET16RH002049--01.jpg)

5NMMCET16RH002049(2)/5NMMCET16RH002049--07.jpg)